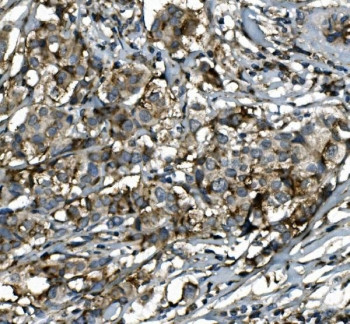
Anti-SGK1

Cookie preferences
This website uses cookies, which are necessary for the technical operation of the website and are always set. Other cookies, which increase the comfort when using this website, are used for direct advertising or to facilitate interaction with other websites and social networks, are only set with your consent.
Configuration
Technically required
These cookies are necessary for the basic functions of the shop.
"Allow all cookies" cookie
"Decline all cookies" cookie
CSRF token
Cookie preferences
Currency change
Customer-specific caching
FACT-Finder tracking
Individual prices
Selected shop
Session
Comfort functions
These cookies are used to make the shopping experience even more appealing, for example for the recognition of the visitor.
Note
Show the facebook fanpage in the right blod sidebar
Statistics & Tracking
Affiliate program
Conversion and usertracking via Google Tag Manager
Track device being used
| Item number | Size | Datasheet | Manual | SDS | Delivery time | Quantity | Price |
|---|---|---|---|---|---|---|---|
| NSJ-RQ5922 | 100 µg | - | - |
3 - 10 business days* |
790.00€
|
If you have any questions, please use our Contact Form.
You can also order by e-mail: info@biomol.com
Larger quantity required? Request bulk
You can also order by e-mail: info@biomol.com
Larger quantity required? Request bulk
0.5mg/ml if reconstituted with 0.2ml sterile DI water. Serine/threonine-protein kinase Sgk1 also... more
Product information "Anti-SGK1"
0.5mg/ml if reconstituted with 0.2ml sterile DI water. Serine/threonine-protein kinase Sgk1 also known as serum and glucocorticoid-regulated kinase 1 is an enzyme that in humans is encoded by the SGK1 gene. It is mapped to 6q23.2. This gene encodes a serine/threonine protein kinase that plays an important role in cellular stress response. This kinase activates certain potassium, sodium, and chloride channels, suggesting an involvement in the regulation of processes such as cell survival, neuronal excitability, and renal sodium excretion. High levels of expression of this gene may contribute to conditions such as hypertension and diabetic nephropathy. Several alternatively spliced transcript variants encoding different isoforms have been noted for this gene. Protein function: Serine/threonine-protein kinase which is involved in the regulation of a wide variety of ion channels, membrane transporters, cellular enzymes, transcription factors, neuronal excitability, cell growth, proliferation, survival, migration and apoptosis. Plays an important role in cellular stress response. Contributes to regulation of renal Na(+) retention, renal K(+) elimination, salt appetite, gastric acid secretion, intestinal Na(+)/H(+) exchange and nutrient transport, insulin-dependent salt sensitivity of blood pressure, salt sensitivity of peripheral glucose uptake, cardiac repolarization and memory consolidation. Up-regulates Na(+) channels: SCNN1A/ENAC, SCN5A and ASIC1/ACCN2, K(+) channels: KCNJ1/ROMK1, KCNA1-5, KCNQ1-5 and KCNE1, epithelial Ca(2+) channels: TRPV5 and TRPV6, chloride channels: BSND, CLCN2 and CFTR, glutamate transporters: SLC1A3/EAAT1, SLC1A2 /EAAT2, SLC1A1/EAAT3, SLC1A6/EAAT4 and SLC1A7/EAAT5, amino acid transporters: SLC1A5/ASCT2, SLC38A1/SN1 and SLC6A19, creatine transporter: SLC6A8, Na(+)/dicarboxylate cotransporter: SLC13A2/NADC1, Na(+)-dependent phosphate cotransporter: SLC34A2/NAPI-2B, glutamate receptor: GRIK2/GLUR6. Up-regulates carriers: SLC9A3/NHE3, SLC12A1/NKCC2, SLC12A3/NCC, SLC5A3/SMIT, SLC2A1/GLUT1, SLC5A1/SGLT1 and SLC15A2/PEPT2. Regulates enzymes: GSK3A/B, PMM2 and Na(+)/K(+) ATPase, and transcription factors: CTNNB1 and nuclear factor NF-kappa-B. Stimulates sodium transport into epithelial cells by enhancing the stability and expression of SCNN1A/ENAC. This is achieved by phosphorylating the NEDD4L ubiquitin E3 ligase, promoting its interaction with 14-3-3 proteins, thereby preventing it from binding to SCNN1A/ENAC and targeting it for degradation. Regulates store-operated Ca(+2) entry (SOCE) by stimulating ORAI1 and STIM1. Regulates KCNJ1/ROMK1 directly via its phosphorylation or indirectly via increased interaction with SLC9A3R2/NHERF2. Phosphorylates MDM2 and activates MDM2-dependent ubiquitination of p53/TP53. Phosphorylates MAPT/TAU and mediates microtubule depolymerization and neurite formation in hippocampal neurons. Phosphorylates SLC2A4/GLUT4 and up- regulates its activity. Phosphorylates APBB1/FE65 and promotes its localization to the nucleus. Phosphorylates MAPK1/ERK2 and activates it by enhancing its interaction with MAP2K1/MEK1 and MAP2K2/MEK2. Phosphorylates FBXW7 and plays an inhibitory role in the NOTCH1 signaling. Phosphorylates FOXO1 resulting in its relocalization from the nucleus to the cytoplasm. Phosphorylates FOXO3, promoting its exit from the nucleus and interference with FOXO3-dependent transcription. Phosphorylates BRAF and MAP3K3/MEKK3 and inhibits their activity. Phosphorylates SLC9A3/NHE3 in response to dexamethasone, resulting in its activation and increased localization at the cell membrane. Phosphorylates CREB1. Necessary for vascular remodeling during angiogenesis. Sustained high levels and activity may contribute to conditions such as hypertension and diabetic nephropathy. Isoform 2 exhibited a greater effect on cell plasma membrane expression of SCNN1A/ENAC and Na(+) transport than isoform 1. [The UniProt Consortium]
| Keywords: | Anti-SGK, Anti-SGK1, EC=2.7.11.1, Anti-Serine/threonine-protein kinase Sgk1, Anti-Serum/glucocorticoid-regulated kinase 1, SGK1 Antibody |
| Supplier: | NSJ Bioreagents |
| Supplier-Nr: | RQ5922 |
Properties
| Application: | WB, IHC (paraffin), IF, FC |
| Antibody Type: | Polyclonal |
| Conjugate: | No |
| Host: | Rabbit |
| Species reactivity: | human |
| Immunogen: | Amino acids LIAFMKQRRMGLNDFIQKIANNS from the human protein |
| Format: | Purified |
Database Information
| KEGG ID : | K13302 | Matching products |
| UniProt ID : | O00141 | Matching products |
| Gene ID : | GeneID 6446 | Matching products |
Handling & Safety
| Storage: | +4°C |
| Shipping: | +4°C (International: +4°C) |
Caution
Our products are for laboratory research use only: Not for administration to humans!
Our products are for laboratory research use only: Not for administration to humans!
Information about the product reference will follow.
more
You will get a certificate here
Viewed

